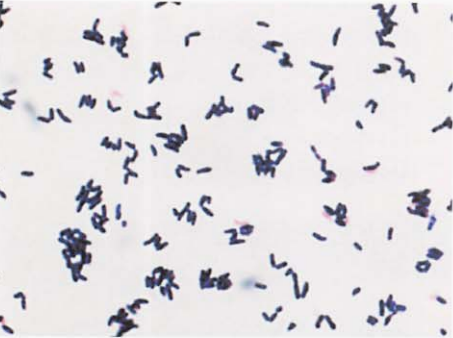
图 1假白喉棒杆菌纯培养物的镜下形态(革兰染色)
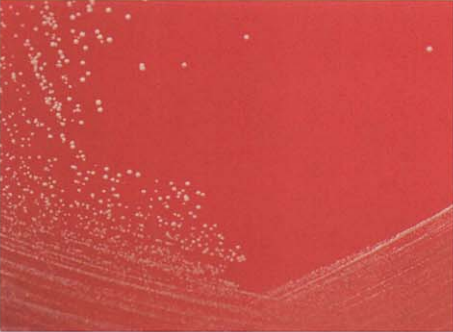
图 3假白喉棒杆菌在血琼脂平板上的菌落特征(48h)
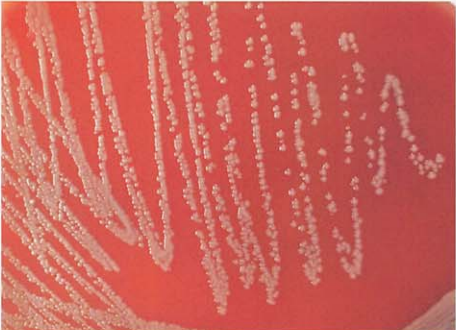
图 9纹带棒杆菌在血琼脂平板上菌落特征(18~24h)
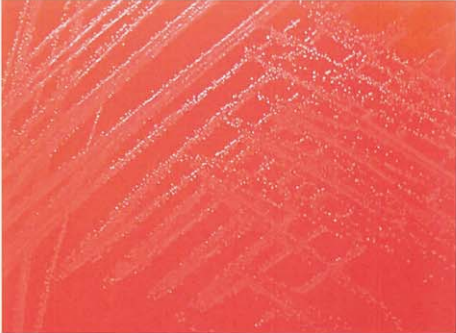
图 11杰氏棒杆菌在血琼脂平板上菌落特征(18~24h)
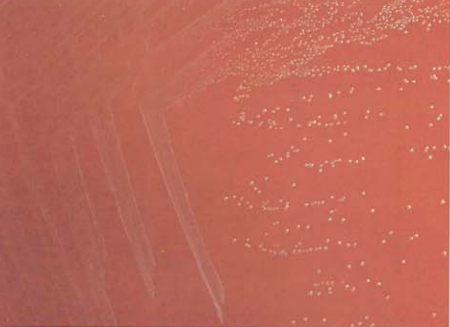
图 13解脲棒杆菌在血琼脂平板上的菌落特征(18~24h)

假白喉棒杆菌、马氏棒杆菌、硬质小麦棒杆菌和纹带棒杆菌的生理生化特性介绍
来源:武汉市灰藻生物科技有限公司 浏览量:34 发布时间:2026-03-02 13:24:33
一、假白喉棒杆菌(C. pseudodiphtheriticum)
(一)假白喉棒杆菌形态与染色
革兰阳性粗短杆菌,多形性不明显,染色均匀,少有异染颗粒(图 1)。
图 1假白喉棒杆菌纯培养物的镜下形态(革兰染色)
(二)假白喉棒杆菌培养特性
在血琼脂平板上35℃培养18~24 h,形成中等大小、灰白色、不溶血菌落(图 2、图 3)。

图 2 假白喉棒杆菌在血琼脂平板上的菌落特征(24h)
图 3 假白喉棒杆菌在血琼脂平板上的菌落特征(48h)
(三)假白喉棒杆菌生化反应
触酶试验阳性,主要生化反应见表 1。
| 试验 | 结果 | 试验 | 结果 |
|---|---|---|---|
| 氧化/发酵 | O | 葡萄糖 | – |
| 硝酸盐 | + | 麦芽糖 | – |
| 脲酶 | + | 吡嗪酰胺酶 | + |
| 蔗糖 | – | 碱性磷酸酶 | V |
| 七叶苷 | – | CAMP试验 | – |
注:+,90%以上菌株阳性;–,90%以上菌株阴性;V,11%~89%菌株阳性;O,氧化
(四)假白喉棒杆菌鉴别要点
1. 本菌特征:革兰阳性棒杆菌,栅栏状排列,不分解糖类,触酶、脲酶和马尿酸钠试验阳性。
2. 与白喉棒杆菌的鉴别:见表 2。
| 菌名 | 氧化/发酵 | 脲酶 | 葡萄糖 | 麦芽糖 | 吡嗪酰胺酶 |
|---|---|---|---|---|---|
| 假白喉棒杆菌 | O | + | – | – | + |
| 白喉棒杆菌 | F | – | + | + | – |
注:+,90%以上菌株阳性;–,90%以上菌株阴性;O,氧化;F,发酵
(五)药敏试验的药物种类选择
药敏试验的药物种类选择参见白喉棒杆菌章节。
(六)结果解释与要点提示
假白喉棒杆菌是寄居于人体鼻腔、咽喉部的正常菌群,不产生毒素,偶尔可引起心内膜炎、尿路感染等。
二、马氏棒杆菌(C. matruchotii)
(一)马氏棒杆菌形态与染色
革兰阳性杆菌,在丝状的末端与一根短杆相连,形似“鞭子柄”状(图 4)。

图 4 马氏棒杆菌纯培养镜下形态(革兰染色)
(二)马氏棒杆菌培养特性
在血琼脂平板上35℃培养18~24 h,形成扁平、丝状、蜘蛛样小菌落。
(三)马氏棒杆菌生化反应
触酶试验阳性,主要生化反应见表 3。
| 试验 | 结果 | 试验 | 结果 |
|---|---|---|---|
| 氧化/发酵 | F | 葡萄糖 | + |
| 硝酸盐 | + | 麦芽糖 | + |
| 脲酶 | – | 吡嗪酰胺酶 | + |
| 蔗糖 | + | 碱性磷酸酶 | – |
| 七叶苷 | V | CAMP试验 | – |
注:+,90%以上菌株阳性;–,90%以上菌株阴性;V,11%~89%菌株阳性;F,发酵
(四)马氏棒杆菌鉴别要点
本菌特征:革兰阳性杆菌形似“鞭子柄”,触酶、硝酸盐还原试验阳性,分解葡萄糖。
(五)马氏棒杆菌药敏试验的药物种类选择
药敏试验的药物种类选择参见白喉棒杆菌章节。
(六)马氏棒杆菌结果解释与要点提示
马氏棒杆菌是一种少见的条件致病菌,偶尔从人的呼吸道分离到。如发现有附着于较大杆菌的纤细细菌,则可断定其为马氏棒杆菌,因为这种菌在活体内也常形成特征性的“鞭子柄”形态。
三、硬质小麦棒杆菌(C. durum)
(一)硬质小麦棒杆菌形态与染色
革兰阳性长丝状细杆菌(图 5)。

图 5硬质小麦棒杆菌纯培养的镜下形态(革兰染色)
(二)硬质小麦棒杆菌培养特性
在木炭缓冲酵母浸膏琼脂平板上,35℃培养48~72 h,形成直径0.5~1 mm、米色、粗糙、有卷褶、边缘不整齐、紧密黏于琼脂的菌落。
(三)硬质小麦棒杆菌生化反应
触酶试验阳性,主要生化反应见表 4。
| 试验 | 结果 | 试验 | 结果 |
|---|---|---|---|
| 木糖 | – | 葡萄糖 | + |
| 硝酸盐 | + | 麦芽糖 | + |
| 触酶 | + | 吡嗪酰胺酶 | + |
| 蔗糖 | + | 碱性磷酸酶 | – |
注:+,90%以上菌株阳性;–,90%以上菌株阴性
(四)硬质小麦棒杆菌鉴定要点
本菌特征:革兰阳性长丝状细杆菌,生长缓慢,触酶试验阳性,分解葡萄糖。
(五)硬质小麦棒杆菌药敏试验的药物种类选择
药敏试验的药物种类选择参见白喉棒杆菌章节。
(六)硬质小麦棒杆菌结果解释与要点提示
到目前为止,仅从人呼吸道标本中分离到硬质小麦棒杆菌。
四、纹带棒杆菌(C. striatum)
(一)纹带棒杆菌形态与染色
革兰阳性杆菌,V形、栅栏状,单个或成双排列(图 6)。痰标本直接涂片查见革兰阳性杆菌(图 7)。血培养阳性培养物直接涂片查见革兰阳性杆菌(图 8)。

图 6纹带棒杆菌在血琼脂平板上纯培养镜下形态(革兰染色)

图 7 痰标本中纹带棒杆菌的镜下形态(革兰染色)

图 8 含树脂血培养瓶涂片(革兰染色)
(二)纹带棒杆菌培养特性
在血琼脂平板上35℃培养18~24 h,形成中等大小、奶油色、不溶血的菌落(图 9)。
图 9纹带棒杆菌在血琼脂平板上菌落特征(18~24h)
(三)纹带棒杆菌生化反应
触酶试验阳性,主要生化反应见表 5。
| 试验 | 结果 | 试验 | 结果 |
|---|---|---|---|
| 氧化/发酵 | F | 葡萄糖 | + |
| 硝酸盐 | + | 麦芽糖 | – |
| 脲酶 | – | 吡嗪酰胺酶 | + |
| 蔗糖 | V | 碱性磷酸酶 | + |
| 七叶苷 | – | CAMP试验 | V |
注:+,90%以上菌株阳性;–,90%以上菌株阴性;V,11%~89%菌株阳性;F,发酵
(四)纹带棒杆菌鉴别要点
1. 本菌特征:革兰阳性杆菌,栅栏状排列,分解葡萄糖,不分解其他糖类,触酶和马尿酸钠试验阳性。
2. 与白喉棒杆菌的鉴别:白喉棒杆菌分解麦芽糖,而纹带棒杆菌不分解。
3. 与化脓链球菌的鉴别:两者镜下形态相似,而纹带棒杆菌触酶阳性,化脓链球菌触酶阴性。
(五)纹带棒杆菌药敏试验的药物种类选择
药敏试验的药物种类选择参见白喉棒杆菌章节。
(六)纹带棒杆菌结果解释与要点提示
纹带棒杆菌一般是人或动物鼻腔、咽喉部等处的正常菌群。近年来国外有学者报道,免疫抑制剂和现代化检查手段的广泛使用,导致纹带棒杆菌、无枝菌酸棒杆菌、G群棒杆菌、白喉棒杆菌(不产毒素)、杰氏棒杆菌、假白喉棒杆菌、解脲棒杆菌所致的医院感染明显增多,可引起血流感染,应引起临床重视。
血培养中检出纹带棒杆菌,首先检查是单侧瓶还是双侧瓶。若单侧,则怀疑抽血时污染,若双侧瓶,仅单侧培养阳性时应与临床联系,了解患者情况(是否发热,白细胞计数,是否有免疫缺陷等),排除污染后再进一步鉴定。
五、杰氏棒杆菌(C. jeikeium)
(一)杰氏棒杆菌形态染色
革兰阳性杆菌,V形、栅栏状,单个或成双等排列(图 10)。

图 10杰氏棒杆菌在血琼脂平板上纯培养镜下形态(革兰染色)
(二)杰氏棒杆菌培养特性
在血琼脂平板上35℃培养18~24 h,形成极小、不凸起、完整、浅灰白色的菌落(图 11)。
图 11杰氏棒杆菌在血琼脂平板上菌落特征(18~24h)
(三)杰氏棒杆菌生化反应
触酶试验阳性,主要生化反应见表 6。
| 试验 | 结果 | 试验 | 结果 |
|---|---|---|---|
| 氧化/发酵 | O | 葡萄糖 | + |
| 硝酸盐 | – | 麦芽糖 | V |
| 脲酶 | – | 吡嗪酰胺酶 | + |
| 蔗糖 | – | 碱性磷酸酶 | + |
| 七叶苷 | – | CAMP试验 | – |
注:+,90%以上菌株阳性;–,90%以上菌株阴性;V,11%~89%菌株阳性;O,氧化
(四)杰氏棒杆菌鉴别要点
1. 本菌特征:革兰阳性杆菌,栅栏状排列,分解葡萄糖,不分解其他糖类,触酶、吡嗪酰胺酶和碱性磷酸酶试验阳性。
2. 与马氏棒杆菌的鉴别:马氏棒杆菌分解麦芽糖和硝酸盐试验阳性,而杰氏棒杆菌相反。
(五)杰氏棒杆菌药敏试验的药物种类选择
药敏试验的药物种类选择参见白喉棒杆菌章节。
(六)杰氏棒杆菌结果解释与要点提示
(1)杰氏棒杆菌是临床标本中最常见的棒杆菌,文献报道了其在医院内的传播。RapID CB Plus及API Coryne系统(如果用辅助试验)可准确地鉴定杰氏棒杆菌。
(2)该菌通常表现为多重耐药,包括β-内酰胺类、大环内酯类、氨基糖苷类、氟喹诺酮类、四环素、克林霉素等,但对替考拉宁、万古霉素敏感。
(3)杰氏棒杆菌药物治疗选择见表 7。
| 首选 | 次选 | 其他有效药物 |
|---|---|---|
| 万古霉素+氨基糖苷类 万古霉素或替考拉宁 | 青霉素G+氨基糖苷类 | 很多菌株对青霉素耐药 |
注:具体参照《热病:桑福德抗微生物治疗指南》(新译第44版)、《国家抗微生物治疗指南》推荐
六、解脲棒杆菌(C. urealyticum)
(一)解脲棒杆菌形态染色
革兰阳性杆菌,呈V形,单个或成双排列(图 12)。

图 12解脲棒杆菌在血琼脂平板上纯培养的镜下形态(革兰染色)
(二)解脲棒杆菌培养特性
在血琼脂平板上35℃培养18~24 h,形成极微小、凸起、光滑、灰白色的菌落(图 13
图 13解脲棒杆菌在血琼脂平板上的菌落特征(18~24h)
(三)解脲棒杆菌生化反应
触酶试验阳性,主要生化反应见表 8。
| 试验 | 结果 | 试验 | 结果 |
|---|---|---|---|
| 氧化/发酵 | O | 葡萄糖 | – |
| 硝酸盐 | – | 麦芽糖 | – |
| 脲酶 | + | 吡嗪酰胺酶 | + |
| 蔗糖 | – | 碱性磷酸酶 | V |
| 七叶苷 | – | CAMP试验 | – |
注:+,90%以上菌株阳性;–,90%以上菌株阴性;V,11%~89%菌株阳性;O,氧化
(四)解脲棒杆菌鉴别要点
1. 本菌特征:革兰阳性杆菌,栅栏状排列,不分解任何糖类,脲酶、吡嗪酰胺酶试验阳性。
2. 与杰氏棒杆菌的鉴别:解脲棒杆菌脲酶试验阳性,不分解葡萄糖,而杰氏棒杆菌相反。
(五)解脲棒杆菌药敏试验的药物种类选择
药敏试验的药物种类选择参见白喉棒杆菌章节。
(六)解脲棒杆菌结果解释与要点提示
解脲棒杆菌是临床标本分离出来的最常见的棒杆菌之一。商业鉴定系统(RapID CB Plus及API Coryne系统)可准确地鉴定解脲棒杆菌。
参考文献
周庭银, 章强强 主编. 临床微生物学诊断与图解(第4版)[M]. 上海: 上海科学技术出版社, 2019.
相关产品
HZB916207:假白喉棒杆菌 | Corynebacterium pseudodiphtheriticum
HZB137487:马氏棒杆菌 | Corynebacterium matruchotii
HZB362675:硬质小麦棒杆菌 | Corynebacterium durum
HZB360631:纹带棒杆菌 | Corynebacterium striatum
敬请关注灰藻生物,共筑健康未来!
— 武汉市灰藻生物科技有限公司团队敬上
灰藻生物:我们期待着与客户共同成长,共创生命科学的美好未来!
更新日期:2026-02-26
编制人:木木
审稿人:小藻